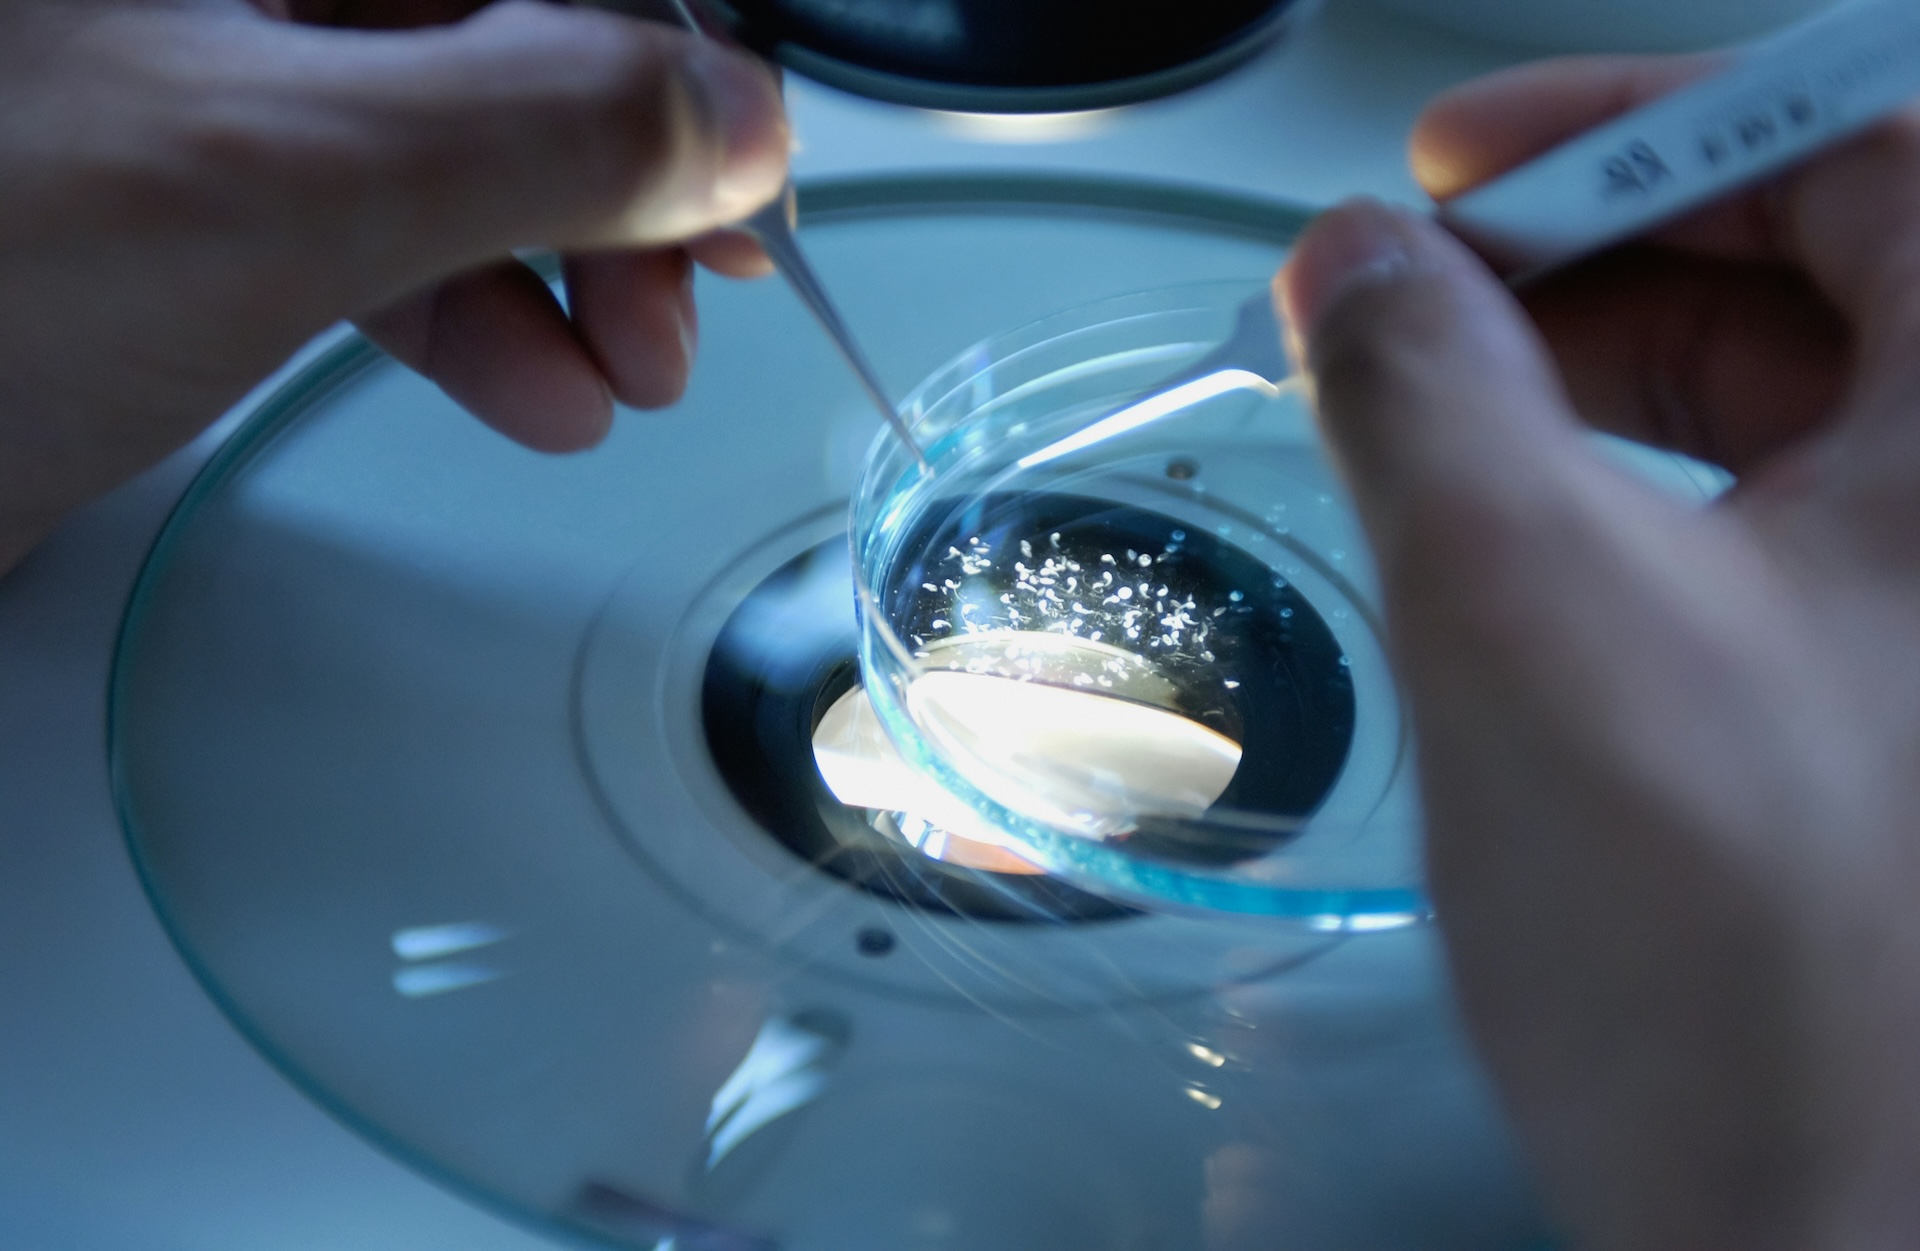
Example resource

Lorem ipsum dolor sit amet, pro ornatus principes efficiendi id, ei ius vidit posidonium comprehensam. Eam eu quem alia vocibus. Dissentias deterruisset te usu, veri corpora est an, eos eirmod saperet luptatum ei. In mea nisl erat utroque. Causae quaestio ea usu, an...
Resources
Let’s take disclosure off your to-do list.
Get in touch to see how we can manage your trial registrations and results efficiently, accurately, and with full compliance.